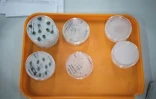
Des boîtes de pétri contenant des graines à stockerà la Kew Millennium Seed Bank, le 25 avril 2023 Wakehurst, au sud de Londres
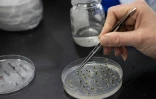
Une scientifique fait germer des graines pour vérifier leur état de santé après avoir été stockées à la Kew Millennium Seed Bank, le 25 avril 2023 à Wakehurst, au sud de Londres

Les chambres fortes se trouvent sous terre, à une température de -20 degrés et elles peuvent résister à des inondations et des bombardements. A l'intérieur, un trésor de 40.000 espèces de graines de plantes sauvages du monde entier, pour beaucoup menacées.
Le Millenium Seed Bank (MSB) a engagé une course contre la montre car, selon des scientifiques, deux espèces végétales sur cinq sont menacées d'extinction.
Ce centre, qui se trouve dans la campagne anglaise au sud de Londres, est la plus grande banque de graines du monde.
Pour le documentariste David Attenborough, une sommité dans le monde des sciences naturelles, le MSB est "peut-être l'initiative de conservation la plus importante jamais réalisée".
"L'objectif est de conserver des espèces sauvages à travers les graines, pour éviter que ces espèces ne disparaissent à long terme", explique le professeur John Dickie, responsable de ce projet.
Ce chercheur de 70 ans suit depuis ses débuts le MSB, inauguré en l'an 2000 pour célébrer le millénaire.
Il se trouve à Wakehurst, une antenne du célèbre jardin botanique de Kew Gardens à l'ouest de Londres.
Au total, 2,5 milliards de graines y sont stockées. Elles sont de toutes formes, couleurs, tailles. Elles appartiennent à 40.020 espèces différentes et viennent de 190 pays.
Près de 20% de la flore mondiale y est conservée. La priorité est donnée aux plantes menacées, notamment par le changement climatique.
Mais aussi aux plantes endémiques, qui ne peuvent être trouvées que dans une zone géographique spécifique. Celles qui sont utiles aux populations, d'un point médical ou économique, ont aussi leur place.
"Les espèces végétales sont menacées pour plusieurs raisons, (...) surtout la modification de l'utilisation des sols, pour l'agriculture, et, de plus en plus, le changement climatique", explique John Dickie. "Certaines plantes vont s'adapter, d'autres non. (...) Au moins, elles seront ici, plutôt que ne plus exister du tout".
- Radiations -
Chaque semaine, Wakehurst reçoit de nouvelles graines en provenance des quatre coins du monde. Et alors commence le processus pour les conserver.
"Notre conservation des espèces sauvages s'appuie sur la technologie qui était déjà utilisée pour les espèces cultivées", explique John Dickie.
"Ce n'est pas sorcier: il faut sécher, nettoyer et congeler". Une fois congelées, les graines peuvent être conservées des décennies, probablement des siècles, dit-il.
L'équipe de John Dickie travaille sous le regard du public, dans leur laboratoire vitré à Wakehurst. Ils sont une petite vingtaine de chercheurs et quelques bénévoles.
Lucy Taylor travaille sur des graines arrivées de Madagascar, des Albizia polyphylla.
"Madagascar est un lieu très intéressant pour les biologistes car il y a là une flore unique comme l'île qui s'est détachée de l'Afrique. Par ailleurs, la pression sur la terre y est importante" du fait de l'agriculture, explique-t-elle.
Lucy Taylor sépare les graines vides des autres. "Beaucoup sont vides ou infestées d'insectes ou de maladies. (...) Or nous voulons une collection de la meilleure qualité possible et la place dans nos coffres est limitée", explique la chercheuse.
Les graines sont passées au rayon X pour repérer des maladies.
Chacune a sa carte d'identité, avec son nom, son pays d'origine, sa date d'arrivée au MSB. Elles sont rangées dans des bocaux en verre avant d'être congelées dans les chambres fortes souterraines, construites pour résister aux inondations, aux bombardements, aux radiations.
Les scientifiques y rentrent couverts comme s'ils étaient sur une base du pôle nord ou du pôle sud.
La plus grande collection de graines est celle de la famille des orchidées.
Mais il y a bien sûr des plantes rares, comme le plus petit nénuphar du monde, ou le Deschampsia antarctica aussi appelé l'herbe de cheveux de l'Antarctique, une des deux plantes à fleurs indigènes du continent gelé.
Le MSB, qui reçoit des financements publics et des donations, a passé des partenariats avec 90 pays. Quelques uns, comme l'Indonésie, refusent de partager leurs graines avec le MSB, mais les conservent sur leur territoire. D'autres, en revanche, semblent hors d'atteinte. L'un des rares regrets de John Dickie est ainsi de n'avoir aucun échange avec l'Iran.
 AFP